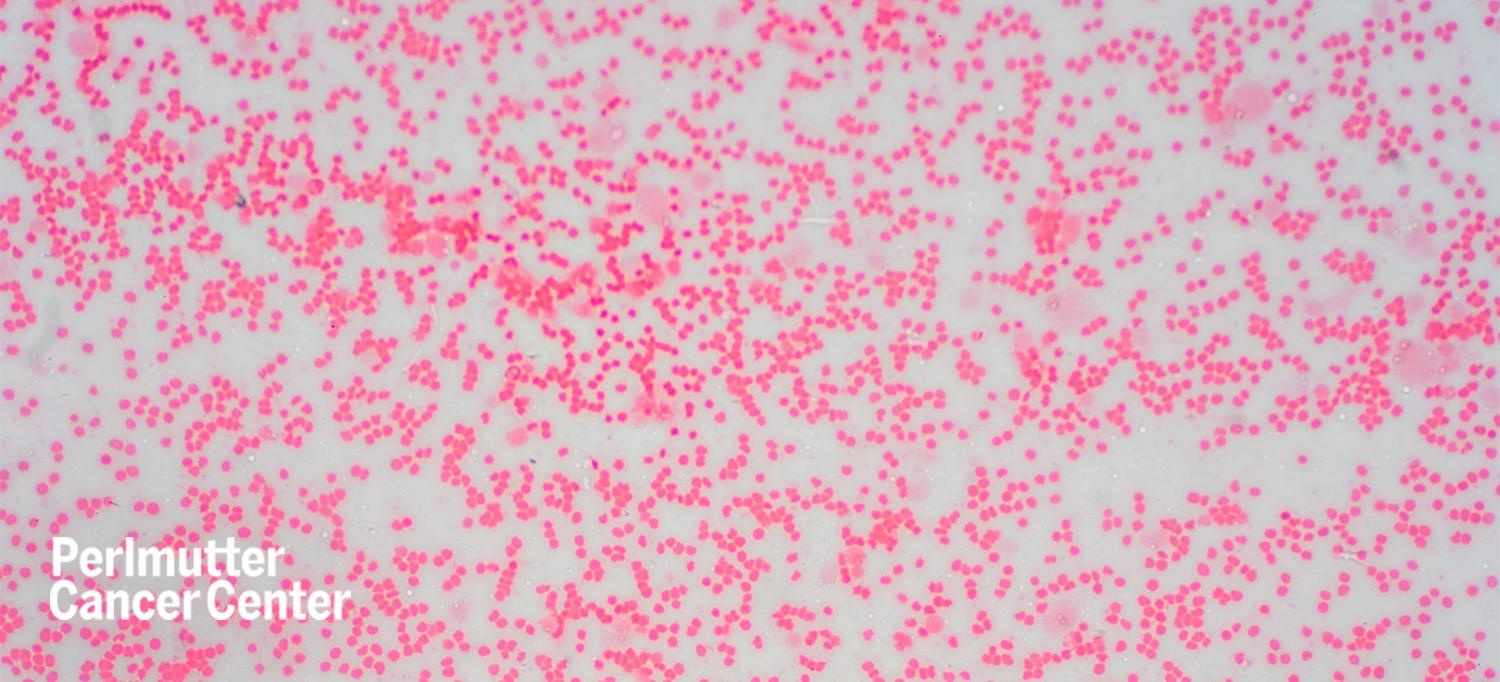

Photo: tonaquatic/Getty
A bone marrow transplant is the only treatment that can result in remission for people with myelodysplastic syndromes, conditions that could develop into acute myeloid leukemia. In a bone marrow transplant, bone marrow and blood cells are completely replaced by someone else’s bone marrow and blood cells. Jun H. Choi, MD, a hematologist–oncologist at NYU Langone Health’s Perlmutter Cancer Center, notes that due to the strong chemotherapy required to wipe out all the bone marrow and blood cells, recipients have to be fit and relatively young, which usually means people less than 70 years of age.
“This is a relatively intense therapy, and you need to be pretty strong to tolerate this,” says Dr. Choi, also a clinical assistant professor in the Department of Medicine at NYU Grossman School of Medicine.
Watch and read more on SurvivorNet.

